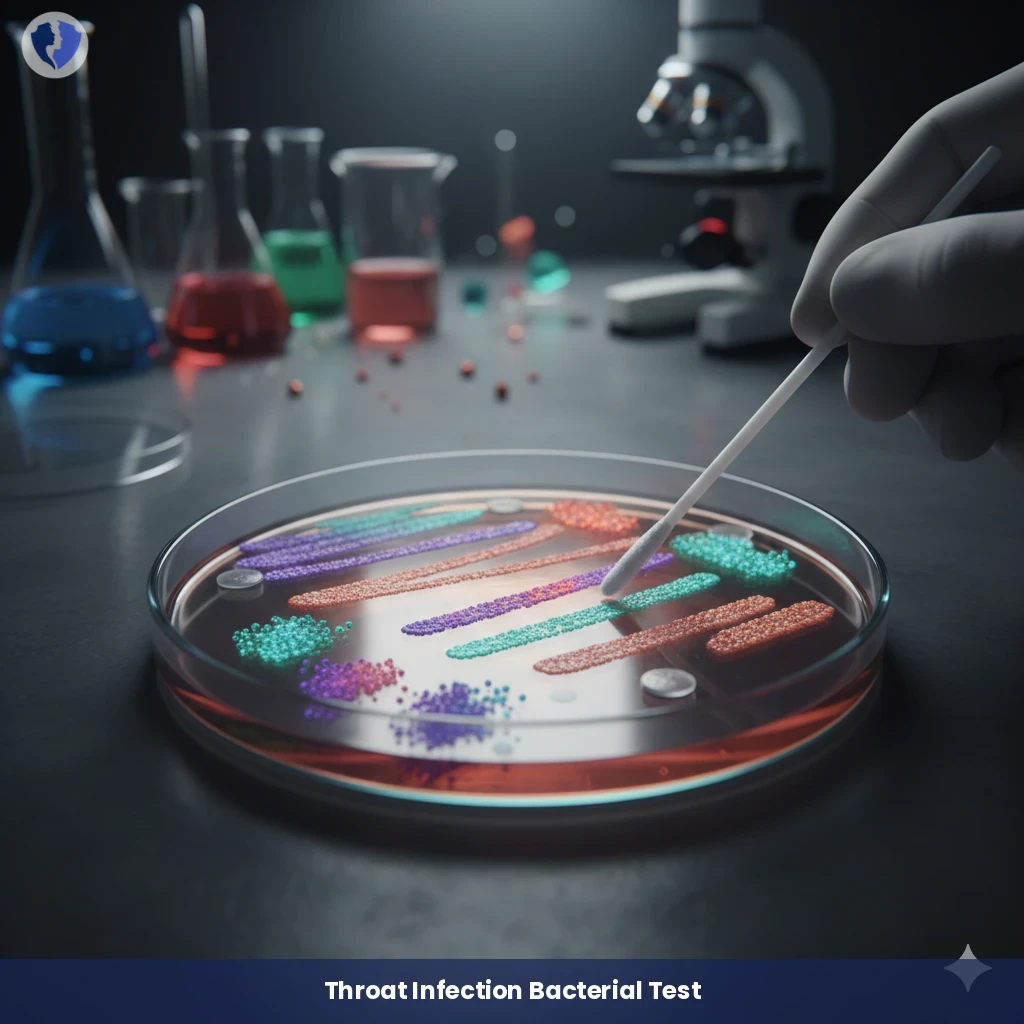
Throat Bacteria & Antibiotic Sensitivity - Throat Swab Culture and Sensitivity

Service Details
Throat Bacteria & Antibiotic Sensitivity - Throat Swab Culture and Sensitivity
A microbiological examination involves collecting a sample from the back of the throat and tonsils using a sterile swab, then culturing it on selective culture media to encourage the growth of pathogenic bacteria, particularly group A streptococcus (Streptococcus pyogenes). If growth is positive, antibiotic susceptibility testing is performed to determine the most effective drug for eradicating the isolated bacteria, thus guiding precise treatment and helping to prevent complications such as rheumatic fever.